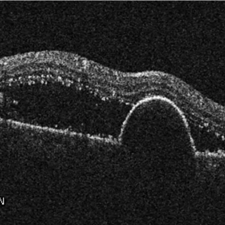

-
 Retinal Detachment
Retinal Detachment
Mar 22 2015 by Andrea Arriola-Lopez, MD MSc
Fundus photograph of a 38-year-old female patient with RD and PVR C. Inferior tear was found near to ora.
Photographer: Andrea Elizabeth Arriola López, MSc. Asociación para Evitar la Ceguera, I.A.P. México D.F.
Imaging device: OPTOS, Dakota.
Condition/keywords: full thickness retinal tear, proliferative vitreoretinopathy (PVR)
-
 Cone Dystrophy
Cone Dystrophy
Mar 22 2015 by Andrea Arriola-Lopez, MD MSc
Fundus autofluorescence of an 31-year-old male with cone dystrophy.
Photographer: Andrea Elizabeth Arriola López, MSc. Asociación para Evitar la Ceguera, I.A.P. México D.F.
Imaging device: OPTOS, Dakota.
Condition/keywords: autofluorescence imaging, cone dystrophy, fundus autofluorescence (FAF), macula, macula lesion
-
 Lens displacement
Lens displacement
Jun 1 2015 by Andrea Arriola-Lopez, MD MSc
Anterior segment photograph of a 24-year-old female with crystalline lens displacement, showing zonula fibers opposite to the direction of the lens.
Photographer: Andrea Elizabeth Arriola, MSc. Asociacion para evitar la ceguera en México IAP
Condition/keywords: dislocated crystalline lens, lens
-
 Diabetic Retinopathy
Diabetic Retinopathy
Aug 21 2015 by Andrea Arriola-Lopez, MD MSc
Color fundus photography shows neovascularization of the optic nerve head, macular pre retinal hemorrhage, pan retinal photocoagulation and extreme temporal peripherical retina without PRP.
Photographer: Andrea Elizabeth Arriola L.
Imaging device: OPTOS Dakota
Condition/keywords: diabetes, diabetic retinopathy, neovascularization (NV)
-
 CRVO
CRVO
Sep 7 2015 by Andrea Arriola-Lopez, MD MSc
Color fundus photography of right eye with central retinal vein occlusion; BCVA 20/25; IOP 16mmHg. No macular edema or neovascularization.
Photographer: Andrea Elizabeth Arriola López, MD, MSc
Imaging device: OPTOS Dakota
Condition/keywords: blot hemorrhages, central retinal vein occlusion (CRVO), venous tortuosity
-
 Dislocated Lens
Dislocated Lens
Sep 7 2015 by Andrea Arriola-Lopez, MD MSc
Color fundus photography of right eye of a 54-year-old man, with history of blunt trauma seven month ago. VA HM. IOP 18mmHg. There is no peripherical lesions or traction.
Photographer: Andrea Elizabeth Arriola López, MD, MSc
Imaging device: OPTOS Dakota
Condition/keywords: blunt trauma, dislocated crystalline lens, lens dislocation
-
 Lamellar Macular Hole
Lamellar Macular Hole
Nov 26 2015 by Andrea Arriola-Lopez, MD MSc
76-year-old man, VA CF OD. Central scotoma. Spectralis OCT shows lamellar macular hole (typical schisis in retinal layers).
Photographer: Andrea Elizabeth Arriola MD, MSc
Imaging device: Spectralis OCT, Heidelberg Systems
Condition/keywords: lamellar macular hole, macular hole
-
 Vascular Anormalities
Vascular Anormalities
Jan 6 2016 by Andrea Arriola-Lopez, MD MSc
77-year-old man. Decrease of visual acuity OS. VA 20/30 IOP 14mmHg. Fundus examination findings: Hard exudates, microaneurysms near to fovea. OCT shows IRF. Late leakage on FA.
Photographer: Andrea Elizabeth Arriola-Lopez, MSc MD
Condition/keywords: abnormal retinal vessel, aneurysm, hard exudates, vascular anomaly
-
 Choroidal hemangioma
Choroidal hemangioma
Jan 6 2016 by Andrea Arriola-Lopez, MD MSc
Fundus photograph and FA of 14-year-old girl with macular choroidal hemangioma previously treated with PDT three years ago. Hipofluorescence are due to pigmentary changes.
Photographer: Andrea Elizabeth Arriola-Lopez, MD MSc
Imaging device: Heidelberg Engineering
Condition/keywords: choroidal hemangioma, macular changes, photodynamic therapy
-
Retinal Pigment Epithelium Detachment
Retinal Pigment Epithelium Detachment
Jan 26 2016 by Andrea Arriola-Lopez, MD MSc
89-year-old woman, VA 20/800, IOP 13 mmHg. OCT showed subretinal fluid and PED. Anti-VEGF was administrated.
Photographer: Andrea Elizabeth Arriola MD, MSc
Imaging device: Cirrus
Condition/keywords: neovascular age-related macular degeneration (AMD), neovascularization (NV), sub-retinal pigment epithelium (RPE)
-
 Combined Hamartoma
Combined Hamartoma
Feb 29 2016 by Andrea Arriola-Lopez, MD MSc
40 year-old man with diminished VA since 6 month ago. Fundus examination revealed macular folds, yellow-whitish elevated lesion at the fovea and a subretinal hemorrhage.
Photographer: Andrea Elizabeth Arriola-Lopez MD, MSc
Imaging device: OPTOS Dakota
Condition/keywords: combined hamartoma, macula, subretinal hemorrhage
-
 Choroideremia
Choroideremia
Feb 29 2016 by Andrea Arriola-Lopez, MD MSc
35-year-old man VA 20/50 OU IOP 12mmHg.
Photographer: Andrea Elizabeth Arriola-LopezMD, MSc
Imaging device: OPTOS Dakota
Condition/keywords: choroideremia, retinal pigment epithelium
-
 Angioid Streaks
Angioid Streaks
May 11 2016 by Andrea Arriola-Lopez, MD MSc
64-year-old man, VA CF AO. Inactive neovascularization. Color fundus and red free photograph.
Photographer: Andrea E. Arriola-Lopez MD MSc
Imaging device: Visucam lite Zeiss
Condition/keywords: angioid streaks, color fundus photograph, neovascularization (NV), red-free
-
 Chronic Retinal Detachment
Chronic Retinal Detachment
May 11 2016 by Andrea Arriola-Lopez, MD MSc
56-year-old man, BCVA 20/25. Incidental finding. Laser was given.
Photographer: Andrea E. Arriola-López MD MSc
Imaging device: OPTOS Dakota
Condition/keywords: chronic
-
 Blunt Trauma
Blunt Trauma
May 18 2016 by Andrea Arriola-Lopez, MD MSc
26-year-old man, old ocular blunt trauma. VA HM OD. IOP 14mmHg. Traumatic partial aniridia, cataract and phacodonesys. Ophthalmoscopy showed diffuse hemovitreous, Retina remained attached.
Photographer: Andrea E. Arriola-López MD MSc
Condition/keywords: aniridia, cataract, trauma, traumatic cataract
-
 Lens Bite
Lens Bite
May 30 2016 by Andrea Arriola-Lopez, MD MSc
32-year-old man underwent a vitrectomy due hemovitreous. There was a dense retrolental membrane, while aspirating it, a little bite to lens was done. We decided not to performed lensectomy. VA is 20/30 two months later.
Photographer: Andrea E. Arriola-López MD MSc
Condition/keywords: lens, lens opacity
-
 Retinal Folds After Surgery
Retinal Folds After Surgery
Jun 23 2016 by Andrea Arriola-Lopez, MD MSc
45-year-old man with history of rhegmatogenous retinal detachment and segmental scleral buckle from MIX to MXII, SF6 and cryotherapy on right eye was performed. Radial folds on indentation was seen after surgery. Three weeks later, inferior macular folds was found. The patient was asymptomatic. Observation was decided. Retina remains attach. On top, close up to macular area shows inferior folds far from fovea. Bottom, red free photograph shows no RPE changes on the same retina fold area.
Photographer: Andrea E. Arriola-López MD MSc
Imaging device: OPTOS
Condition/keywords: macular fold, retina surgery, scleral buckle
-
 Retinal Detachment on Retinitis
Retinal Detachment on Retinitis
Sep 14 2016 by Andrea Arriola-Lopez, MD MSc
33-year-old man, with decreased VA since 3 months ago. HIV+, HAART therapy, CD4 257, virus load undetectable. No ocular previous history. On fundus examination there were macular folds, SRF, and a thinning of temporal peripheral retina AO. There was not hemorrhages, cotton wool spots or any other lesion. Vitrectomy + silicon oil was performed, multiples holes was found on the thinning area of retinal detachment. VA three weeks later was 20/150.
Photographer: Andrea E. Arriola-López MD MSc
Imaging device: OPTOS Dakota
Condition/keywords: CMV retinitis, retinitis
-
 Luxated IOL
Luxated IOL
Dec 16 2016 by Andrea Arriola-Lopez, MD MSc
56-year-old woman, PO posterior capsular rupture and sulcus IOL cataract surgery. Blurred vision, no pain. Found out a dropped IOL on a vitrectomized eye.
Photographer: Andrea Elizabeth Arriola-Lopez MD MSc
Imaging device: OR photo
Condition/keywords: dislocated intraocular lens (IOL), dislocated posterior chamber intraocular lens (PCIOL)
-
 Subretinal PFO
Subretinal PFO
Feb 7 2017 by Andrea Arriola-Lopez, MD MSc
SD OCT of 32-year-old woman two weeks after vitrectomy. Round SRF was found. VA 20/50.
Photographer: Andrea Elizabeth Arriola-Lopez MD MSc
Imaging device: Heidelberg SD-OCT
Condition/keywords: perfluorocarbon fluid
-
 Retinoblastoma Regression
Retinoblastoma Regression
Mar 31 2017 by Andrea Arriola-Lopez, MD MSc
Color photograph shows retinoblastoma regression following treatment.
Photographer: Andrea Elizabeth Arriola-Lopez MD MSc
Imaging device: RetCam II
Condition/keywords: atrophic scar, retinoblastoma
-
 Subluxated cataract
Subluxated cataract
Jan 6 2018 by Andrea Arriola-Lopez, MD MSc
72-year-old man with bilateral progressive visual loss. Subluxated cataract was found in OD. Lensectomy and vitrectomy will be done.
Photographer: Andrea E. Arriola-López MD MSc
Condition/keywords: diabetes, subluxation of lens
-
 Vitreous in AC
Vitreous in AC
Jan 9 2018 by Andrea Arriola-Lopez, MD MSc
78-year-old male. Vision loss in OD. IOP 18 mmHg. Subluxated PCIOL and vitreous in anterior chamber was found.
Photographer: Andrea E. Arriola López MD MS
Condition/keywords: anterior chamber, dislocated intraocular lens (IOL), vitreous
-
 Tractional Retinal Detachment
Tractional Retinal Detachment
Mar 10 2018 by Andrea Arriola-Lopez, MD MSc
28-year-old woman with DM type I. OS VA 1/200, IOP 16 mmHg. 23G PPV + silicon oil was performed.
Photographer: Fidel Gudiel MD
Imaging device: Mobile device
Condition/keywords: diabetes, tractional retinal detachment
-
 ILM Peeling
ILM Peeling
Sep 26 2018 by Andrea Arriola-Lopez, MD MSc
65-year-old male, after PPV due to epiretinal membrane. Air filled. 1 week post-op.
Photographer: Lourdes Guambo MD, Centro Oftalmológico León, UFM.
Condition/keywords: air-filled, epiretinal membrane (ERM), internal limiting membrane (ILM) peeling, vitreous cavity
-
 BRVO
BRVO
Sep 26 2018 by Andrea Arriola-Lopez, MD MSc
Color fundus and red free photographs OD. Ghost vessels and shunts are shown.
Photographer: Lourdes Guambo MD
Condition/keywords: branch retinal vein occlusion (BRVO), ghost vessels, occlusion of retinal vein, shunts vessels
-
 Epiretinal Membrane
Epiretinal Membrane
Sep 26 2018 by Andrea Arriola-Lopez, MD MSc
45-year-old woman, BCVA 20/80 OS. Indirect ophthalmoscopy revealed epiretinal membrane, macular folds and traction. PPV was scheduled.
Photographer: Lourdes Guambo MD, Centro Oftalmológico León, UFM.
Condition/keywords: epiretinal membrane (ERM), vitreomacular interface disorders, vitreomacular traction (VMT)
-
 Toxoplasmosis Scar
Toxoplasmosis Scar
Aug 24 2021 by Andrea Arriola-Lopez, MD MSc
Pigmented retinochoroidal scar temporal to fovea.
Condition/keywords: inactive toxoplasmosis, ocular toxoplasmosis
-
 Leber's miliary aneurysms
Leber's miliary aneurysms
Apr 21 2023 by Andrea Arriola-Lopez, MD MSc
26 year-old male with vision loss, his fundus examination showed aneurysmal dilatations with lipid exudation.
Imaging device: ZEISS Clarus Wide Field
Condition/keywords: aneurysm, Leber's miliary aneurysm
-
 Bleeding Laser
Bleeding Laser
Nov 8 2025 by Andrea Arriola-Lopez, MD MSc
26 year-old male, reports seeing a red dot with his left eye after staring at a projector light. BCVA 0.7 logMar.
Photographer: Dr. Waldemar Godoy, Clínica Godoy. Jalapa, Guatemala.
Imaging device: OPTOPOL SD-OCT
Condition/keywords: subhyaloid blood, subhyaloid hemorrhage

A project from the American Society of Retina Specialists